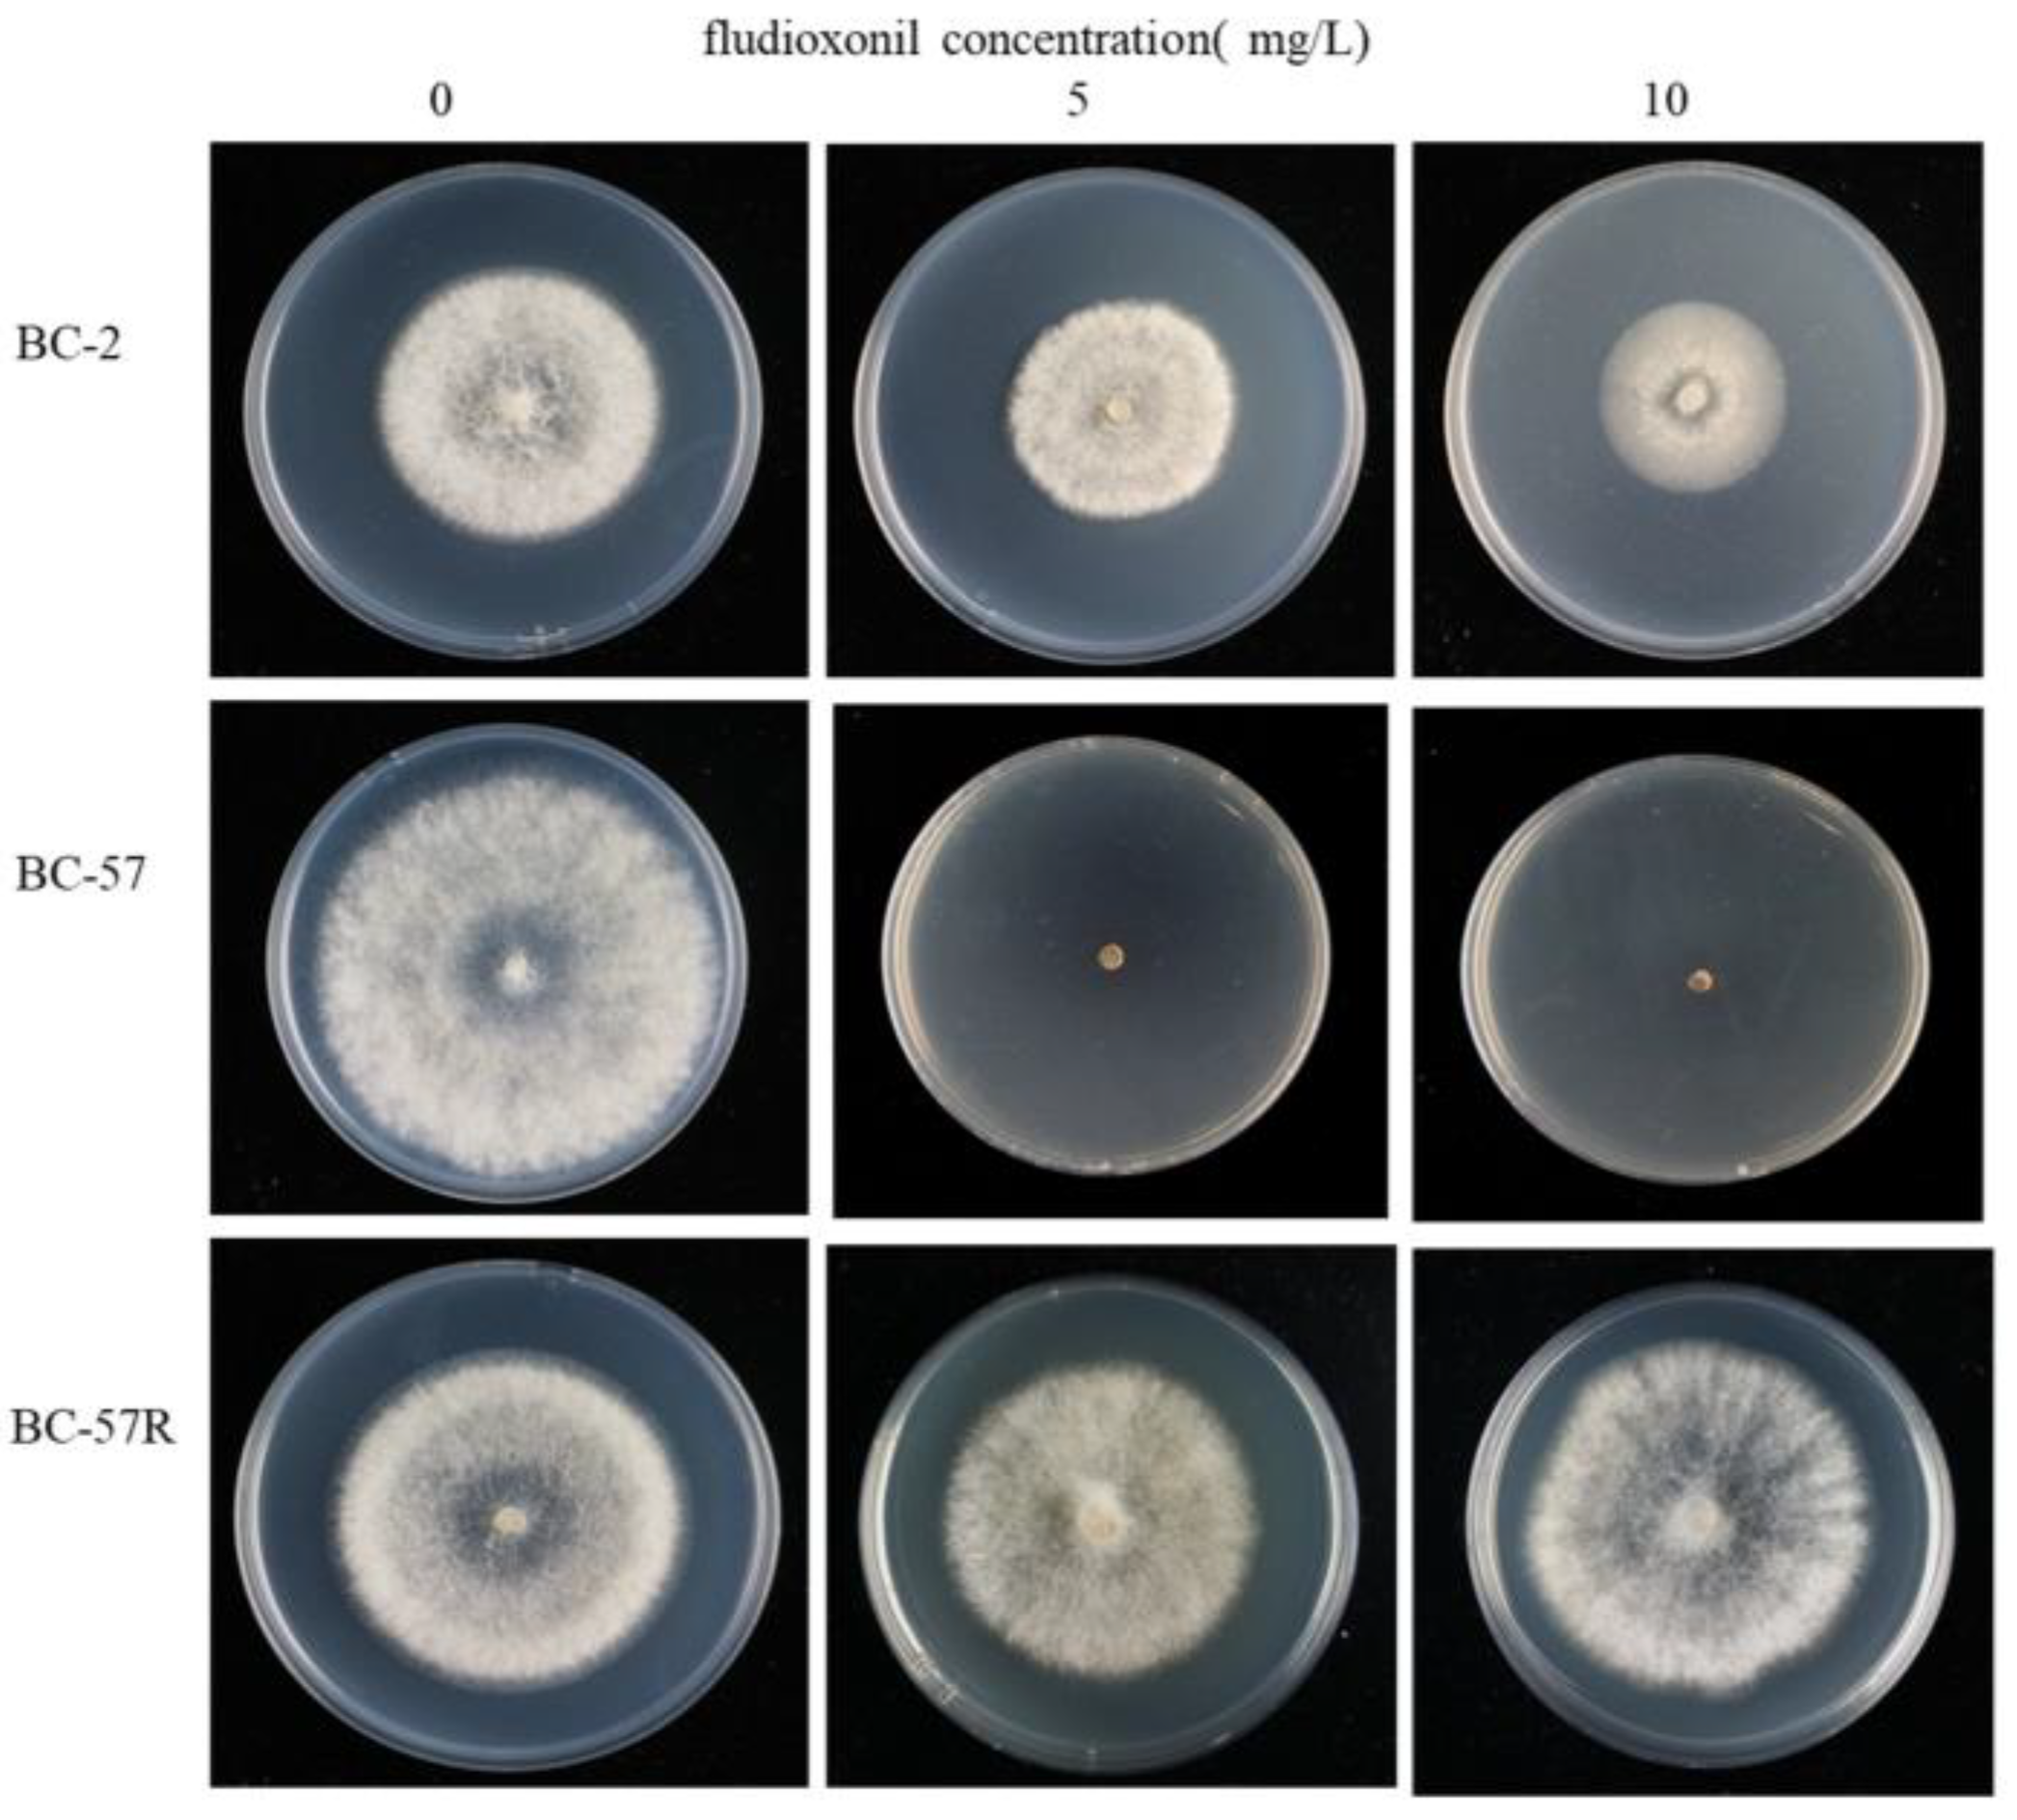

Transcriptomic Analysis of Resistant and Wild-Type Botrytis cinerea Isolates Revealed Fludioxonil-Resistance Mechanisms
Abstract
1. Introduction
2. Results
2.1. Generation of the Fludioxonil-Resistant Mutants
2.2. Identification of the Expressed Transcripts
2.3. Identification of the Differentially Expressed Genes Using RNA-Sequencing
2.4. Functional Distribution of the DEGs
2.5. GO and KEGG Pathway Enrichment Analyses
2.6. Real-Time Quantitative PCR (qRT-PCR) Validation of Fludioxonil-Responsive DEGs
3. Discussion
4. Materials and Methods
4.1. Culturing of Botrytis Cinerea and the Media Preparation
4.2. Fungicide
4.3. Assessment of Growth of BC-2 and BC-57 Cultures on Discriminatory Concentrations of Fludioxonil
4.4. Generation of the Fludioxonil-Resistant Botrytis Cinerea Strains from the In Vitro Cultures
4.5. Stability of the Fludioxonil-Resistant Mutants
4.6. Fludioxonil Treatments
4.7. Extraction of the RNA and RNA Sequencing
4.8. Analysis of Differential Expressed Genes
4.9. GO and KEGG Pathway Analyses
4.10. Gene Expression Using qRT-PCR
5. Conclusions
Supplementary Materials
Author Contributions
Funding
Institutional Review Board Statement
Informed Consent Statement
Data Availability Statement
Conflicts of Interest
References
- Williamson, B.; Tudzynski, B.; Tudzynski, P.; van-Kan, J.A. Botrytis cinerea: The cause of grey mould disease. Mol. Plant Pathol. 2007, 8, 561–580. [Google Scholar] [CrossRef] [PubMed]
- Nazarov, P.A.; Baleev, D.N.; Ivanova, M.I.; Sokolova, L.M.; Karakozova, M.V. Infectious Plant Diseases: Etiology, Current Status, Problems and Prospects in Plant Protection. Acta Nat. 2020, 12, 46–59. [Google Scholar] [CrossRef]
- Dean, R.; van-Kan, J.A.; Pretorius, Z.A.; Hammond-Kosack, K.E.; Di, P.A.; Spanu, P.D.; Rudd, J.J.; Dickman, M.; Kahmann, R.; Ellis, J.; et al. The Top 10 fungal pathogens in molecular plant pathology. Mol. Plant Pathol. 2012, 13, 414–430. [Google Scholar] [CrossRef] [PubMed]
- Petrasch, S.; Silva, C.J.; Mesquida-Pesci, S.D.; Gallegos, K.; van-den Abeele, C.; Papin, V.; Fernandez-Acero, F.J.; Knapp, S.J.; Blanco-Ulate, B. Infection strategies deployed by Botrytis cinerea, Fusarium acuminatum, and Rhizopus stolonifer as a function of tomato fruit ripening stage. Front. Plant Sci. 2019, 10, 223. [Google Scholar] [CrossRef] [PubMed]
- Wei, Y.; Xu, M.; Wu, H.; Tu, S.; Pan, L.; Tu, K. Defense response of cherry tomato at different maturity stages to combined treatment of hot air and Cryptococcus laurentii. Postharvest Biol. Technol. 2016, 117, 177–186. [Google Scholar] [CrossRef]
- Zhang, X.; Min, D.; Li, F.; Ji, N.; Meng, D.; Li, L. Synergistic effects of L-arginine and methyl salicylate on alleviating postharvest disease caused by Botrysis cinerea in tomato fruit. J. Agric. Food Chem. 2017, 65, 4890–4896. [Google Scholar] [CrossRef]
- Sun, G.; Yang, Q.; Zhang, A.; Guo, J.; Liu, X.; Wang, Y.; Ma, Q. Synergistic effect of the combined bio-fungicides ε-poly-l-lysine and chitooligosaccharide in controlling grey mould Botrysis cinerea tomatoes. Int. J. Food Microbiol. 2018, 276, 46–53. [Google Scholar] [CrossRef] [PubMed]
- Walter, M.; Harris-Virgin, P.; Morgan, C.; Stanley, J.; Body-Wilson, K.H.; Langford, G.I. Fungicides for control of flower and berry infections of Botrytis cinerea in boysenbery. Crop Protec. 2005, 24, 625–631. [Google Scholar] [CrossRef]
- Holz, G.; Gutschow, M.; Coertze, S.; Calitz, F.J. Occurrence of Botrytis cinerea and subsequent disease suppression at different positions on leaves and bunches of grape. Plant Dis. 2003, 87, 351–358. [Google Scholar] [CrossRef]
- Leroux, P.; Fritz, R.; Debieu, D.; Albertini, C.; Lanen, C.; Bach, J.; Gredt, M.; Chapeland-Leclerc, F. Mechanisms of resistance to fungicides in field strains of Botrytis cinerea. Pest Manag. Sci. 2002, 58, 876–888. [Google Scholar] [CrossRef]
- Sang, C.; Ren, W.; Wang, J.; Xu, H.; Zhang, Z.; Zhou, M.; Chen, C.; Wang, K. Detection and fitness comparison of target-based highly fludioxonil-resistant isolates of Botrytis cinerea from strawberry and cucumber in China. Pestic. Biochem. Physiol. 2018, 147, 110–118. [Google Scholar] [CrossRef] [PubMed]
- Katan, T.; Elad, Y.; Yunis, H. Resistance to diethofencarb (NPC) in benomyl-resistant field isolates of Botrytis cinerea. Plant Pathol. 1989, 38, 86–92. [Google Scholar] [CrossRef]
- Latorre, B.A.; Spadaro, I.; Rioja, M.E. Occurrence of resistance strains of Botrytis cinerea to anilinopyrimidine fungicides in table grapes in Chile. Crop Prot. 2002, 21, 957–961. [Google Scholar] [CrossRef]
- Myresiotis, C.K.; Karaoglanidia, G.S.; Tzavella-Klonari, K. Resistance of Botrytis cinerea isolates from vegetable crops to anilinopyrimidine, phenylpyrrole, hydroxyani-lide, benzimidazole, and dicarboximide fungicides. Plant Dis. 2007, 91, 407–413. [Google Scholar] [CrossRef] [PubMed]
- Oshima, M.; Banno, S.; Okada, K.; Takeuchi, T.; Kimura, M.; Ichiishi, A.; Yamaguchi, I.; Fujimura, M. Survey of mutations of a histidine kinase gene BcOS1 in dicarboximide-resistant field isolates of Botrytis cinerea. J. Gen. Plant Pathol. 2006, 72, 65–73. [Google Scholar] [CrossRef]
- Raposo, R.; Delcan, J.; Gomez, V.; Melgarejo, P. Distribution and fitness of isolates of Botrytis cinerea with multiple fungicide resistance in Spanish greenhouses. Plant Pathol. 1996, 45, 497–505. [Google Scholar] [CrossRef]
- Zhao, H.; Kim, Y.K.; Huang, L.; Xiao, C. Resistance to thiabendazole and baseline sensitivity to fludioxonil and pyrimethanil in Botrytis cinerea populations from apple and pear in Washington State. Postharvest Biol. Technol. 2010, 56, 12–18. [Google Scholar] [CrossRef]
- Li, X.; Fernández-Ortuño, D.; Grabke, A.; Schnabel, G. Resistance to fludioxonil in Botrytis cinerea isolates from blackberry and strawberry. Phytopathology 2014, 104, 724–732. [Google Scholar] [CrossRef]
- Saito, S.; Xiao, C. Fungicide resistance in Botrytis cinerea populations in California and its influence on control of gray mold on stored mandarin fruit. Plant Dis. 2018, 102, 2545–2549. [Google Scholar] [CrossRef]
- Leroux, P. Recent developments in the mode of action of fungicides. Pest. Manag. Sci. 1996, 47, 191–197. [Google Scholar] [CrossRef]
- Pillonel, C.; Meyer, T. Effect of phenylpyrroles on glycerol accumulation and protein kinase activity of Neurospora crassa. Pestic. Sci. 1997, 49, 229–236. [Google Scholar] [CrossRef]
- Gehmann, K.; Nyfeler, R.; Leadbeater, A.J.; Nevill, D.J.; Sozzi, D. CGA173506: A new phenylpyrrole fungicide for broad-spectrum disease control. In Brighton Crop Protection Conference, Pests and Diseases—1990; British Crop Protection Council: Alton, UK, 1990; Volume 2, pp. 399–406. [Google Scholar]
- Bahn, Y.S. Master and commander in fungal pathogens: The two-component system and the HOG signaling pathway. Eukaryot. Cell 2008, 7, 2017–2036. [Google Scholar] [CrossRef] [PubMed]
- Viaud, M.; Fillinger, S.; Liu, W.; Polepalli, J.S.; Le, P.P.; Kunduru, A.R.; Leroux, P.; Legendre, L. A class III histidine kinase acts as a novel virulence factor in Botrytis cinerea. Mol. Plant-Microbe Interact. 2006, 19, 1042–1050. [Google Scholar] [CrossRef] [PubMed]
- Furukawa, K.; Randhawa, A.; Kaur, H.; Mondal, A.K.; Hohmann, S. Fungal fludioxonil sensitivity is diminished by a constitutively active form of the group III histidine kinase. FEBS Lett. 2012, 586, 2417–2422. [Google Scholar] [CrossRef]
- Lew, R.R. Turgor and net ion flux responses to activation of the osmotic MAP kinase cascade by fludioxonil in the filamentous fungus Neurospora crassa. Fungal Genet. Biol. 2010, 47, 721–726. [Google Scholar] [CrossRef]
- Jespers, A.K.; Davidse, L.C.; De-Waard, M.A. Interference of the phenylpyrrole fungicide fenpiclonil with membranes and membrane function. Pestic. Sci. 1994, 40, 133–140. [Google Scholar] [CrossRef]
- Jespers, A.K.; Davidse, L.C.; De-Waard, M.A. Effect of fenpiclonil on phosphorylation of glucose in Fusarium sulphureum. Pestic. Sci. 1995, 44, 167–175. [Google Scholar] [CrossRef]
- Catlett, N.L.; Yoder, O.C.; Turgeon, B.G. Whole-genome analysis of two-component signal transduction genes in fungal pathogens. Eukaryot. Cell 2003, 2, 1151–1161. [Google Scholar] [CrossRef]
- Avenot, H.; Simoneau, P.; Iacomi-Vasilescu, B.; Bataille, S.N. Characterization of mutations in the two-component histidine kinase gene AbNIK1 from Alternaria brassicicola that confer high dicarboximide and phenylpyrrole resistance. Curr. Genet. 2005, 47, 234–243. [Google Scholar] [CrossRef]
- Schumacher, M.M.; Enderlin, C.S.; Selitrennikoff, C.P. The osmotic-1 locus of Neurospora crassa encodes a putative histidine kinase similar to osmosensors of bacteria and yeast. Curr. Microbiol. 1997, 34, 340–347. [Google Scholar] [CrossRef]
- Alex, L.A.; Borkovich, K.A.; Simon, M.I. Hyphal development in Neurospora crassa: Involvement of a two-component histidine kinase. Proc. Natl. Acad. Sci. USA 1996, 93, 3416–3421. [Google Scholar] [CrossRef] [PubMed]
- Miller, T.K.; Renault, S.; Selitrennikoff, C.P. Molecular dissection of alleles of the osmotic-1 locus of Neurospora crassa. Fungal Genet. Biol. 2002, 35, 147–155. [Google Scholar] [CrossRef] [PubMed]
- Brewster, J.L.; De-Valoir, T.; Dwyer, N.D.; Winter, E.; Gustin, M.C. An osmosensing signal transduction pathway in yeast. Science 1993, 59, 1760–1763. [Google Scholar] [CrossRef] [PubMed]
- Ren, W.; Shao, W.; Han, X.; Zhou, M.; Chen, C. Molecular and biochemical characterization of laboratory and field mutants of Botrytis cinerea resistant to fludioxonil. Plant Dis. 2016, 100, 1414–1423. [Google Scholar] [CrossRef]
- Sang, H.; Popko, J.T.; Chang, T.; Jung, G. Genetics and resistance molecular mechanisms involved in qualitative and quantitative resistance to the dicarboximide fungicide iprodione in Sclerotinia homoeocarpa field isolates. Phytopathology 2017, 107, 198–207. [Google Scholar] [CrossRef]
- Grabke, A.; Fernández-Ortuńo, D.; Schnabel, G. Fenhexamid resistance in Botrytis cinerea from strawberry fields in the Carolinas is associated with four target gene mutations. Plant Dis. 2013, 97, 271–276. [Google Scholar] [CrossRef]
- Gong, C.; Qin, Y.; Qu, J.; Wang, X. Resistance detection and mechanism of strawberry Botrytis cinerea to fludioxonil in Sichuan province. Sci. Agric. Sin. 2018, 51, 4277–4287. [Google Scholar]
- Zhang, Y.; Lamm, R.; Pillonel, C.; Lam, S.; Xu, J.R. Osmoregulation and fungicide resistance: The Neurospora crassa os-2 gene encodes a HOG1 mitogen-activated protein kinase homologue. Appl. Environ. Microbiol. 2002, 68, 532–538. [Google Scholar] [CrossRef]
- Fujimura, M.; Ochiai, N.; Oshima, M.; Motoyama, T.; Ichiishi, A.; Usami, R.; Horikoshi, K.; Yamaguchi, I. Putative homologs of SSK22 MAPKK kinase and PBS2 MAPK kinase of Saccharomyces cerevisiae encoded by os-4 and os-5 genes for osmotic sensitivity and fungicide resistance in Neurospora crassa. Biosci. Biotechnol. Biochem. 2003, 67, 186–191. [Google Scholar] [CrossRef][Green Version]
- de-Waard, M.A.; Andrade, A.C.; Hayashi, K.; Schoonbeek, H.J.; Stergiopoulos, I.; Zwiers, L.H. Impact of fungal drug transporters on fungicide sensitivity, multidrug resistance and virulence. Pest Manag. Sci. 2006, 62, 195–207. [Google Scholar] [CrossRef]
- Andrade, A.C.; del-Sorbo, G.; van-Nistelrooy, J.M.; de-Waard, M.A. The ABC transporter AtrB from Aspergillus nidulans mediates resistance to all major classes of fungicides and some natural toxic compounds. Microbiology 2000, 146, 1987–1997. [Google Scholar] [CrossRef] [PubMed]
- Kretschmer, M.; Leroch, M.; Mosbach, A.; Walker, A.S.; Fillinger, S.; Mernke, D.; Schoonbeek, H.J.; Pradier, J.M.; Leroux, P.; De-Waard, M.A. Fungicide-driven evolution and molecular basis of multidrug resistance in field populations of the grey mould fungus Botrytis cinerea. PLoS Pathog. 2009, 5, e1000696. [Google Scholar] [CrossRef]
- Leroch, M.; Plesken, C.; Weber, R.S.; Kauff, F.; Scalliet, G.; Hahn, M. Gray mould populations in German strawberry fields are resistant to multiple fungicides and dominated by a novel clade closely related to Botrytis cinerea. Appl. Environ. Microb. 2013, 79, 159–167. [Google Scholar] [CrossRef]
- Mernke, D.; Dahm, S.; Walker, A.S.; Lalève, A.; Fillinger, S.; Leroch, M.; Hahn, M. Two promoter rearrangements in a drug efflux transporter gene are responsible for the appearance and spread of multi-drug resistance phenotype MDR2 in Botrytis cinerea isolates in French and German vineyards. Phytopathology 2011, 101, 1176–1183. [Google Scholar] [CrossRef]
- Hayashi, K.; Schoonbeek, H.J.; de-Waard, M.A. Bcmfs1, a novel major facilitator superfamily transporter from Botrytis cinerea, provides tolerance towards the natural toxic compounds campothecin and cercosporin and towards fungicides. Appl. Environ. Microbiol. 2002, 68, 4996–5004. [Google Scholar] [CrossRef] [PubMed]
- Samaras, A.; Ntasiou, P.; Myresiotis, C.; Karaoglanidis, G. Multidrug resistance of Penicillium expansum to fungicides: Whole transcriptome analysis of MDR strains reveals overexpression of efflux transporter genes. Int. J. Food Microbiol. 2020, 335, 108896. [Google Scholar] [CrossRef] [PubMed]
- Iacomi-Vasilescu, B.; Avenot, H.; Bataille’-Simoneau, N.; Laurent, E.; Gue´nard, M.; Simoneau, P. In vitro fungicide sensitivity of Alternaria species pathogenic to crucifers and identification of Alternaria brassicicola field isolates highly resistant to both dicarboximides and phenylpyrroles. Crop Prot. 2004, 23, 481–488. [Google Scholar] [CrossRef]
- Zhou, F.; Hu, H.; Song, Y.; Gao, Y.; Liu, Q.; Song, P.; Chen, E.; Yu, Y.; Li, D.; Li, C. Biological characteristics and molecular mechanism of fludioxonil resistance in Botrytis cinerea from Henan province of China. Plant Dis. 2020, 104, 1041–1047. [Google Scholar] [CrossRef]
- Kuang, J.; Hou, Y.P.; Wang, J.; Zhou, M.G. Sensitivity of Sclerotinia sclerotiorum to fludioxonil: In vitro determination of baseline sensitivity and resistance risk. Crop Prot. 2011, 30, 876–882. [Google Scholar] [CrossRef]
- Ziogas, B.N.; Markoglou, A.N.; Spyropoulou, V. Effect of phenylpyrrole-resistance mutations on ecological fitness of Botrytis cinerea and their genetical basis in Ustilago maydis. Eur. J. Plant Pathol. 2005, 113, 83–100. [Google Scholar] [CrossRef]
- Ajouz, S.; Nicot, P.C.; Bardin, M. Adaptation to pyrrolnitrin in Botrytis cinerea and cost of resistance. Plant Pathol. 2010, 59, 556–566. [Google Scholar] [CrossRef]
- Taiwo, A.O.; Harper, L.A.; Derbyshire, M.C. Impacts of fludioxonil resistance on global gene expression in the necrotrophic fungal plant pathogen Sclerotinia sclerotiorum. BMC Genom. 2021, 22, 91. [Google Scholar] [CrossRef] [PubMed]
- Grabke, A.; Fernández-Ortuño, D.; Amiri, A.; Li, X.; Peres, N.A.; Smith, P.; Schnabel, G. Characterization of iprodione resistance in Botrytis cinerea from strawberry and blackberry. Phytopathology 2014, 104, 396–402. [Google Scholar] [CrossRef] [PubMed]
- Fillinger, S.; Ajouz, S.; Nicot, P.C.; Leroux, P.; Bardin, M. Functional and structural comparison of pyrrolnitrin-and iprodione induced modifications in the class III histidine-kinase Bos1 of Botrytis cinerea. PLoS ONE 2012, 7, e42520. [Google Scholar] [CrossRef]
- Hu, M.; Cosseboom, S.; Schnabel, G. AtrB-associated fludioxonil resistance in Botrytis fragariae not linked to mutations in transcription factor mrr1. Phytopathology 2019, 109, 839–846. [Google Scholar] [CrossRef] [PubMed]
- Bohnert, S.; Heck, L.; Gruber, C.; Neumann, H.; Distler, U.; Tenzer, S.; Yemelin, A.; Thines, E.; Jacob, S. Fungicide resistance toward fludioxonil conferred by overexpression of the phosphatase gene MoPTP2 in Magnaporthe oryzae. Mol. Microbiol. 2019, 111, 662–677. [Google Scholar] [PubMed]
- Kilani, J.; Fillinger, S. Phenylpyrroles: 30 Years, Two molecules and (nearly) no resistance. Front. Microbiol. 2014, 7, e1001479. [Google Scholar] [CrossRef]
- Cosseboom, S.D.; Ivors, K.L.; Schnabel, G.; Bryson, P.K.; Holmes, G.J. Within season shift in fungicide resistance profiles of Botrytis cinerea in California strawberry fields. Plant Dis. 2018, 103, 59–64. [Google Scholar] [CrossRef]
- Fernández-Ortuño, D.; Grabke, A.; Bryson, P.K.; Amiri, A.; Peres, N.A.; Schnabel, G. Fungicide resistance profiles in Botrytis cinerea from strawberry fields of seven southern US states. Plant Dis. 2014, 98, 825–833. [Google Scholar] [CrossRef]
- Rupp, S.; Weber, R.S.; Rieger, D.; Detzel, P.; Hahn, M. Spread of Botrytis cinerea strains with multiple fungicide resistance in German horticulture. Front. Microbiol. 2017, 7, 2075. [Google Scholar] [CrossRef]
- Hagiwara, D.; Matsubayashi, Y.; Marui, J.; Furukawa, K.; Yamashino, T.; Kanamaru, K.; Kato, M.; Abe, K.; Kobayashi, T.; Mizuno, T. Characterization of the NikA histidine kinase implicated in the phosphorelay signal transduction of Aspergillus nidulans, with special reference to fungicide responses. Biosci. Biotechnol. Biochem. 2007, 71, 844–847. [Google Scholar] [CrossRef] [PubMed]
- Motoyama, T.; Ohira, T.; Kadokura, K.; Ichiishi, A.; Fujimura, M.; Yamaguchi, I.; Kudo, T. An Os-1 family histidine kinase from a filamentous fungus confers fungicide-sensitivity to yeast. Curr. Genet. 2005, 47, 298–306. [Google Scholar] [CrossRef] [PubMed]
- Hahn, M. The rising threat of fungicide resistance in plant pathogenic fungi: Botrytis as a case study. J. Chem. Biol. 2014, 7, 133–141. [Google Scholar] [CrossRef] [PubMed]
- Jun, K.; Fried, L.; Behr, S.; Heermann, R. Histidine kinases and response regulators in networks. Curr. Opin. Microbiol. 2012, 15, 118–124. [Google Scholar]
- Herivaux, A.; So, Y.S.; Gastebois, A.; Latge, J.P.; Bouchar, J.P.; Bahn, Y.S.; Papon, N. Major sensing proteins in pathogenic fungi: The hybrid histidine kinase family. PLoS Pathog. 2016, 12, e1005683. [Google Scholar] [CrossRef]
- Lavin, J.L.; Ramirez, L.; Ussery, D.W.; Pisabarro, A.G.; Oguiza, J.A. Genomic analysis of two-component signal transduction proteinsin basidiomycetes. J. Mol. Microbiol. Biotechnol. 2010, 18, 63–73. [Google Scholar]
- Ochiai, N.; Fujimura, M.; Motoyama, T.; Ichiishi, A.; Usami, R.; Horikoshi, K.; Yamaguchi, I. Characterization of mutations in the two-component histidine kinase gene that confer fludioxonil resistance and osmotic sensitivity in the os-1 mutants of Neurospora crassa. Pest Manag. Sci. 2001, 57, 437–442. [Google Scholar] [CrossRef]
- Alberoni, G.; Collina, M.; Lanen, C.; Leroux, P.; Brunelli, A. Field strains of Stemphylium vesicarium with a resistance to dicarboximide fungicides correlated with changes in a two-component histidine kinase. Eur. J. Plant Pathol. 2010, 128, 171–184. [Google Scholar] [CrossRef]
- Chapeland-Leclerc, F.; Paccallet, P.; Ruprich-Robert, G.; Reboutier, D.; Chastin, C.; Papon, N. Differential involvement of histidine kinase receptors in pseudohyphal development, stress adaptation, and drug sensitivity of the opportunistic yeast. Candida Lusit. Eukaryot. Cell 2007, 6, 1782–1794. [Google Scholar] [CrossRef][Green Version]
- Bahn, Y.S.; Kojima, K.; Cox, G.M.; Heitman, J. A unique fungal two-component system regulates stress responses, drug sensitivity, sexual development, and virulence of Cryptococcus neoformans. Mol. Biol. Cell 2006, 17, 3122–3135. [Google Scholar] [CrossRef]
- Vermeulen, T.; Schoonbeek, H.J.; De-Waard, M.A. The ABC transporter BcatrB from Botrytis cinerea is a determinant of the activity of the phenylpyrrole fungicide fludioxonil. Pest Manag. Sci. 2001, 57, 393–402. [Google Scholar] [CrossRef] [PubMed]
- Hayashi, K.; Schoonbeek, H.J.; Sugiura, H.; De-Waard, M.A. Multidrug resistance in Botrytis cinerea associated with decreased accumulation of the azole fungicide oxpoconazole and increased transcription of the ABC transporter gene BcatrD. Pest Biochem. Physiol. 2001, 70, 168–179. [Google Scholar] [CrossRef]
- Stergiopoulos, I.; Zwiers, L.H.; De-Waard, M.A. The ABC transporter MgAtr4 is a virulence factor of Mycosphaerella graminicola that affects colonization of substomatal cavities in wheat leaves. Mol. Plant Microbe Interact. 2003, 16, 689–698. [Google Scholar] [CrossRef]
- Gupta, A.; Chattoo, B.B. Functional analysis of a novel ABC transporter ABC4 from Magnaporthe grisea. FEMS Microbiol. Lett. 2008, 278, 22–28. [Google Scholar] [CrossRef]
- Stefanato, F.; Abou-Mansour, E.; Buchala, A.; Kretschmer, M.; Mosbach, A.; Matthias, H.; Bochet, G.G.; Métraux, J.P.; Schoonbeek, H.J. The ABC-transporter BcatrB from Botrytis cinerea exports camalexin and is a virulence factor on Arabidopsis thaliana. Plant J. 2009, 58, 499–510. [Google Scholar] [CrossRef] [PubMed]
- Sun, C.; Sures, A.; Deng, Y.; Naqvi, N.I. A multidrug resistance transporter in Magnaporthe is required for host penetration and for survival during oxidative stress. Plant Cell 2006, 18, 3686–3705. [Google Scholar] [CrossRef]
- Zhou, F.; Zhou, H.; Cui, Y.; Hu, H.; Liu, Q.; Liu, R.; Wu, Y.; Li, C.W. Mechanism of Fusarium graminearum resistant to the phenylpyrrole fungicide fludioxonil. Acta Pestic. Sci. 2022, 24, 1393–1401. [Google Scholar]
- de Ramon-Carbonell, M.; Lopez-Perez, M.; Gonzalez-Candelas, L.; Sanchez-Torres, P. PdMFS1 transporter contributes to Penicillium digitatum fungicide resistance and fungal Virulence during citrus fruit infection. J. Fungi 2019, 5, 100. [Google Scholar] [CrossRef]
- Marioni, J.C.; Mason, C.E.; Mane, S.M.; Stephens, M.; Gilad, Y. RNA-seq: An assessment of technical reproducibility and comparison with gene expression arrays. Genome Res. 2008, 18, 1509–1517. [Google Scholar] [CrossRef]
- Benjamini, Y.; Hochberg, Y. Controlling the false discovery rate: A practical and powerful approach to multiple hypothesis testing. J. R. Stat. Soc. B 1995, 57, 289–300. [Google Scholar] [CrossRef]
- de-Hoon, M.L.; Imoto, S.; Nolan, J.; Miyano, S. Open source clustering software. Bioinformatics 2004, 20, 1453–1454. [Google Scholar] [CrossRef] [PubMed]
- Xie, C.; Mao, X.; Huang, J.; Ding, Y.; Wu, J.; Dong, S.; Kong, L.; Gao, G.; Li, C.; Wei, L. KOBAS 2.0: A web server for annotation and identification of enriched pathways and diseases. Nucleic Acids Res. 2011, 39, 316–322. [Google Scholar] [CrossRef] [PubMed]
- Liu, J.; Wang, S.; Qin, T.; Li, N.; Niu, Y.; Li, D.; Yuan, Y.; Geng, H.; Xiong, L.; Liu, D. Whole transcriptome analysis of Penicillium digitatum strains treatmented with prochloraz reveals their drug resistant mechanisms. BMC Genom. 2015, 16, 855. [Google Scholar] [CrossRef] [PubMed]
- Livak, K.J.; Schmittgen, T.D. Analysis of relative gene expression data using real-time quantitative PCR and the 2–ΔΔCt method. Methods 2001, 25, 402–408. [Google Scholar] [CrossRef]

| Isolates or Mutants | Sensitivity x | Origin y | EC50 (mg/L) v | RF w | FSC z | ||
|---|---|---|---|---|---|---|---|
| 1st | 10th | 1st | 10th | ||||
| BC-2 | R | Field mutant | 9.64 | 8.96 | 185.38 | 182.86 | 1.01 |
| BC-57 | S | Field isolate | 0.052 | 0.049 | - | - | - |
| BC-57R | R | Laboratory mutant | >500 | >500 | >9000 | >10,000 | - |
| FPKM Interval | S_4h | SI_4h | LR_4h | LRI_4h | FR_4h | FRI_4h |
|---|---|---|---|---|---|---|
| 0~1 | 4006 (30.76%) | 3849 (29.56%) | 3642 (27.97%) | 3485 (26.76%) | 3335 (25.61%) | 3204 (24.60%) |
| 1~3 | 1490 (11.44%) | 1520 (11.67%) | 1603 (12.31%) | 1552 (11.92%) | 1795 (13.78%) | 1627 (12.49%) |
| 3~15 | 3377 (25.93%) | 3473 (26.67%) | 3811 (29.27%) | 3570 (27.42%) | 4175 (32.06%) | 3992 (30.66%) |
| 15~60 | 2743 (21.06%) | 2706 (20.78%) | 2561 (19.67%) | 2877 (22.09%) | 2417 (18.56%) | 2705 (20.77%) |
| >60 | 1406 (10.80%) | 1474 (11.32%) | 1405 (10.79%) | 1538 (11.81%) | 1300 (9.98%) | 1494 (11.47%) |
| Comparison between Samples | Two-Component Regulatory System | ABC | MFS |
|---|---|---|---|
| SI_4h vs. S_4h | 1 | 1 | 2 |
| LRI_4h vs. LR_4h | 0 | 2 | 2 |
| FRI_4h vs. FR_4h | 1 | 2 | 1 |
| LRI_4h vs. SI_4h | 1 | 4 | 4 |
| FRI_4h vs. SI_4h | 1 | 5 | 6 |
| LR_4h vs. S_4h | 2 | 2 | 3 |
| FR_4h vs. S_4h | 2 | 6 | 3 |
| GO ID (Term) | DEG ID | DEG Name (Go-Annotated) | SI_4h vs. S 4h | LRI_4h vs. LR_4h | FRI_4h vs. FR_4h | LRI_4h vs. SI_4h | FRI_4h vs. SI_4h | LR_4h vs. S_4h | FR_4h vs. S_4h |
|---|---|---|---|---|---|---|---|---|---|
| GO: 0022857 | Bcin11g04460 | BcATRA | - | - | - | −2.2873 | −3.5451 | - | −2.1206 |
| transmembrane transporter activity | Bcin13g00710 | BcATRB | - | 4.0179 | 5.3667 | 4.7159 | 3.5178 | 1.2868 | −1.2429 |
| Bcin 01g01450 | BcATRO | −1.6963 | - | - | 3.6815 | - | - | −1.5275 | |
| Bcin13g02720 | BcATRD | - | - | - | - | −3.0033 | - | −3.1034 | |
| Bcin01g05890 | BMR1 | - | 1.4545 | / | - | −1.4874 | −2.8779 | −2.841 | |
| Bcin07g02180 | BMR3 | - | - | 1.3457 | 1.8037 | - | - | −2.1206 | |
| Bcin13g00710 | BcNMT1 | - | - | - | - | −1.1669 | - | - | |
| Bcin01g09910 | BcMFS1 | 3.1375 | - | - | 1.056 | 3.9527 | 4.4665 | 3.988 | |
| Bcin15g00270 | BcMFSM2 | - | - | - | 4.8133 | 2.2514 | 4.4518 | - | |
| Bcin06g06880 | BcAMF1 | - | - | - | 3.8462 | 1.0813 | - | - | |
| Bcin07g02180 | BcTOP1 | 1.2513 | −1.8846 | - | 1.0937 | −1.0274 | 4.1628 | - | |
| Bcin02g07720 | BcYHK8 | - | −1.4361 | −1.1426 | - | 1.1059 | - | 1.834 | |
| Bcin12g01400 | BcVBA2 | - | - | - | - | 1.3125 | - | 1.0977 | |
| GO: 0003824 | Bcin01g06260 | BOS1 | - | - | - | −1.1507 | - | −1.8025 | −1.2321 |
| catalytic activity | Bcin05g00680 | BcHHK2 | - | - | - | - | −1.3765 | - | - |
| Bcin01g05930 | BcHHK17 | −1.2533 | - | −1.0688 | - | - | −1.4132 | −1.1323 |
Disclaimer/Publisher’s Note: The statements, opinions and data contained in all publications are solely those of the individual author(s) and contributor(s) and not of MDPI and/or the editor(s). MDPI and/or the editor(s) disclaim responsibility for any injury to people or property resulting from any ideas, methods, instructions or products referred to in the content. |
© 2023 by the authors. Licensee MDPI, Basel, Switzerland. This article is an open access article distributed under the terms and conditions of the Creative Commons Attribution (CC BY) license (https://creativecommons.org/licenses/by/4.0/).
Share and Cite
Liu, M.; Peng, J.; Wang, X.; Zhang, W.; Zhou, Y.; Wang, H.; Li, X.; Yan, J.; Duan, L. Transcriptomic Analysis of Resistant and Wild-Type Botrytis cinerea Isolates Revealed Fludioxonil-Resistance Mechanisms. Int. J. Mol. Sci. 2023, 24, 988. https://doi.org/10.3390/ijms24020988
Liu M, Peng J, Wang X, Zhang W, Zhou Y, Wang H, Li X, Yan J, Duan L. Transcriptomic Analysis of Resistant and Wild-Type Botrytis cinerea Isolates Revealed Fludioxonil-Resistance Mechanisms. International Journal of Molecular Sciences. 2023; 24(2):988. https://doi.org/10.3390/ijms24020988
Chicago/Turabian StyleLiu, Mei, Junbo Peng, Xuncheng Wang, Wei Zhang, Ying Zhou, Hui Wang, Xinghong Li, Jiye Yan, and Liusheng Duan. 2023. "Transcriptomic Analysis of Resistant and Wild-Type Botrytis cinerea Isolates Revealed Fludioxonil-Resistance Mechanisms" International Journal of Molecular Sciences 24, no. 2: 988. https://doi.org/10.3390/ijms24020988
APA StyleLiu, M., Peng, J., Wang, X., Zhang, W., Zhou, Y., Wang, H., Li, X., Yan, J., & Duan, L. (2023). Transcriptomic Analysis of Resistant and Wild-Type Botrytis cinerea Isolates Revealed Fludioxonil-Resistance Mechanisms. International Journal of Molecular Sciences, 24(2), 988. https://doi.org/10.3390/ijms24020988
